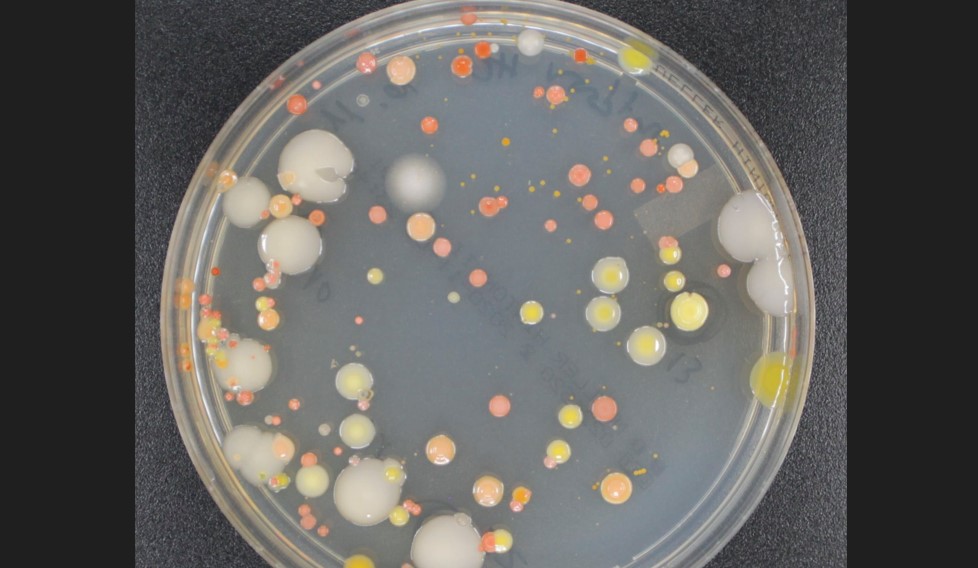

TGW
Guatevision
DCA
Prensa Libre
Canal Antigua
La Hora
Sonora
Al Día
Emisoras Unidas
AGN

El insólito e inquietante descubrimiento de científicos a tres mil metros de altura
El cielo quizá no parezca un lugar prometedor para encontrar vida, pero algunos científicos atravesaron el cielo de Estados Unidos en aviones y capturaron inéditos indicios.
Enlace generado
Resumen Automático
ciencia
|Suscriptores


En una foto sin fecha de Rodó, un vuelo de investigación sobre Japón. En 10 sobrevuelos de Japón, los investigadores descubrieron varias bacterias y hongos. (Foto Prensa Libre: Rodo vía The New York Times)
En los años veinte, algunos científicos atravesaron el cielo de Estados Unidos en aviones y capturaron esporas flotantes. Un siglo después, la atmósfera viviente todavía es un espacio muy misterioso.
El lunes, un grupo de investigadores informó que sobrevoló Japón a altitudes de hasta 3 mil metros y capturó cientos de tipos distintos de bacterias y hongos. El equipo calculó que los microbios habían volado más de 1,900 kilómetros cuando fueron capturados. El aspecto más intrigante es que algunas de las especies podrían causarles enfermedades a los seres humanos.
“Un tercio de las bacterias y un poco más de los hongos pueden considerarse posibles patógenos humanos”, señaló Xavier Rodó, ecólogo computacional del Instituto de Salud Global de Barcelona y principal responsable del estudio.
Rodó advirtió que, a pesar de lo anterior, el nuevo estudio no ofrece ninguna prueba directa de que los microbios de altitudes elevadas puedan causar brotes en los seres humanos al caer al suelo. Sin embargo, aclaró que ofrecía indicios de que los vientos ayudan a propagar las enfermedades. “Es un aspecto al que vale la pena ponerle atención”, comentó.
La idea de los vuelos surgió a partir de la investigación de Rodó sobre una afección misteriosa conocida como enfermedad de Kawasaki, que causa fiebre, sarpullido y, en algunos casos, ataques cardiacos mortales. Desde hace tiempo los investigadores debaten si la causa de la enfermedad es un patógeno, una falla del sistema inmunitario o una combinación de ambos.
Los casos de la enfermedad de Kawasaki se presentan en oleadas. Rodó y sus colegas descubrieron que las oleadas en Japón por lo regular ocurrían cuando llegaban corrientes de viento del noreste de China. Y cuando esas mismas corrientes llegaban a California, también ahí aumentaban los casos.
“No esperábamos que el viento fuera un factor en realidad, pero se descubrió de una forma que me pareció asombrosa”, afirmó Rodó.
En la región de China de donde provenían las corrientes de viento hay operaciones agrícolas y ganaderas masivas, además de minas a cielo abierto. La investigación parecía indicar que algo viajaba en las corrientes, algo que quizá estaba vivo. “Así que pensé que debíamos buscar qué había ahí”, explicó Rodó.
Su equipo recorrió con un avión Cessna masas de aire que viajaban desde China sobre el mar de Japón. El avión se elevó por encima de la turbulencia de la atmósfera baja hasta llegar a la tropósfera libre, una capa en la que las masas de aire pueden atravesar grandes distancias con rapidez. Al lado del avión se abría una válvula que permitía el flujo del aire por un tubo hacia un filtro en el que quedaron atrapadas partículas transportadas por el aire.
En 10 vuelos, el equipo voló en espiral ascendente y tomó muestras a una altitud de hasta 3 mil metros. Luego, los investigadores llevaron las muestras a su laboratorio, donde utilizaron trajes de bioseguridad y respiradores para evitar cualquier contaminación.
Rodó y sus colegas descubrieron niveles elevados de un mineral raro llamado hafnio, quizá proveniente de minas de China.
Las muestras también contenían esporas fúngicas, además de bacterias pegadas a diminutos granos de polvo. A pesar de la larga travesía de los organismos, algunos todavía estaban vivos y lograron formar colonias en cajas de Petri.
Cuando Rodó y sus colegas extrajeron ADN de los microbios, descubrieron por lo menos 266 tipos de hongos y 305 tipos de bacterias. Muchos de los microbios pertenecen a grupos que crecen en plantas o en el suelo. Algunos tienen una habilidad particular para crecer en suelos muy contaminados.
Otros pertenecen a grupos que se sabe que viven en nuestro cuerpo. Algunos son miembros pacíficos del microbioma humano, mientras que otros pueden causar infecciones dañinas.
Rodó especuló que el noreste de China puede ser una fuente potente de patógenos debido al cultivo y la ganadería a gran escala. La erosión puede producir grandes columnas de polvo. Es posible que algunos microbios del suelo, o incluso de fertilizantes o aguas negras, causen enfermedades.
“Me sorprende el número de patógenos humanos que revelaron”, opinó David Schmale, aerobiólogo del Tecnológico de Virginia que no participó en el estudio. Propuso que quizá en realidad sean parientes inocuos de gérmenes causantes de enfermedades. Aseguró que la mejor opción para determinar su verdadera naturaleza es infectar células humanas o animales de laboratorio.
Rodó indicó que está preparando con sus colegas experimentos para exponer muestras de aire a células pulmonares humanas.
Rodó afirmó que el estudio nuevo no resuelve el misterio de la enfermedad de Kawasaki. Es posible que haya más de un patógeno capaz de disparar la enfermedad; también es posible que los niños se vuelvan vulnerables solo si inhalan contaminación del aire transportada por las mismas corrientes. “Todavía no sabemos qué pasa”, indicó Rodó.
Ahora, Rodó y sus colegas están empleando tecnologías nuevas para analizar sus muestras de Japón y están descubriendo evidencia de otros organismos, incluidos virus.
CONTENIDO PARA SUSCRIPTORES
Aun si Rodó y sus colegas encuentran evidencia más clara de patógenos en el viento, queda por determinar si esos gérmenes serían capaces de propagar enfermedades de un lugar a otro. Los patógenos existentes a 3 mil metros de altura están mucho más dispersos que aquellos que se acumulan cuando las personas infectadas exhalan en edificios sin buena ventilación.
De cualquier manera, “algunas veces basta que haya uno”, señaló Schmale. “Estos son espacios ambientales inexplorados, y necesitamos estudiarlos más”.